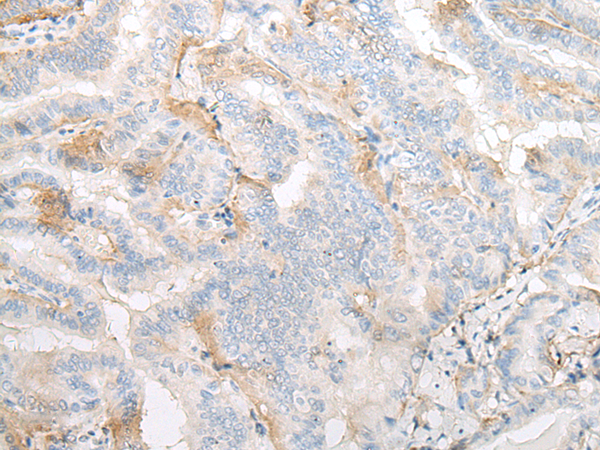

-
分类: 科研抗体货号: P02517别名:应用: WB,IHC反应种属: Human, Mouse, Rat
-
分类: 科研抗体货号: P02633别名: BRI; FBD; ABRI; BRI2; E25B; E3-16; RDGCA; imBRI2; BRICD2B应用: WB反应种属: Human, Mouse, Rat
-
分类: 科研抗体货号: P02579别名: NCB5OR; cb5/cb5R; dJ676J13.1应用: IHC反应种属: Human, Rat
-
分类: 科研抗体货号: P02632别名: FKSG15; IDDM21; TAGAP1; ARHGAP47应用: WB反应种属: Human, Mouse
-
分类: 科研抗体货号: P02660别名: C7orf42应用: WB,IHC反应种属: Human, Mouse, Rat
-
分类: 科研抗体货号: P02574别名: RCP; RCP9; RPC9; CGRPRCP; CGRP-RCP应用: IHC反应种属: Human
-
分类: 科研抗体货号: P02631别名: CS-1; CMH16; C4orf5应用: WB反应种属: Human, Mouse
-
分类: 科研抗体货号: P02652别名: SED5; STX5A应用: WB,IHC反应种属: Human, Mouse, Rat
-
分类: 科研抗体货号: P02686别名: PSD; PSDC; PSSC; DJ858B16; dJ858B16.2应用: IHC反应种属: Human, Mouse, Rat
-
分类: 科研抗体货号: P02630别名: HN3; HsN3; PROS26; PROS-26应用: IHC反应种属: Human, Mouse, Rat

鄂公网安备42018502007531号
鄂公网安备42018502007531号

